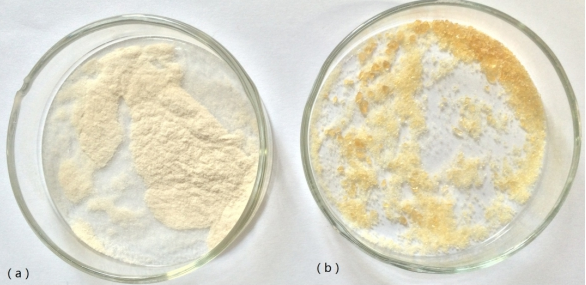

超支化聚合物HBP接枝壳聚糖微球的制备研究毕业论文
2020-06-20 19:13:31
摘 要
壳聚糖在自然界中含量丰富,原料易得,具有很好的生物相容性和生物降解性等性能,是非常具有发展前景的天然高分子材料。超支化聚合物具有独特的准球形分子结构和丰富的端基,表现出高溶解度、低粘度、高反应活性等性能,当前超支化聚合物的应用主要集中在功能材料,药物,涂料中。
本课题依托超支化聚合物丰富的端氨基与壳聚糖分子结构中强反应的氨基和羟基,用马来酸酐做交联剂,将超支化聚合物接枝壳聚糖,制备具有特定结构的超支化接枝壳聚糖微球。制备得到微球后我们通过溶解度、胺值的含量的变化等实验数据来证明超支化聚合物接枝了壳聚糖。
得出如下结论:(1)超支化聚合物接枝壳聚糖能够溶解在三氟乙酸和N,N-二甲基甲酰胺(DMF)复配的溶剂中,不溶解在蒸馏水和冰醋酸中;(2)超支化聚合物接枝壳聚糖的总胺值gt;超支化聚合物总胺值。
关键词:壳聚糖 超支化聚合物 制备 微球
Study on preparation of hyperbranched polymer HBP grafted chitosan microspheres
Abstract
Chitosan is rich in nature, easy to obtain raw materials, with good biocompatibility and biodegradability and other properties, is very promising natural polymer materials. Hyperbranched polymers have unique quasi-spherical molecular structure and rich end groups, showing high solubility, low viscosity, high reactivity and other properties, the current application of hyperbranched polymers are mainly concentrated in functional materials, drugs, coatings.
In this study, the hyperbranched polymer-rich chitosan was grafted with maleic anhydride as the crosslinking agent, Hyperbranched grafted chitosan microspheres. After the microspheres were prepared, we proved that the hyperbranched polymer grafted chitosan by the experimental data such as the solubility and the change of the amine value.
The following conclusions: (1) the hyperbranched polymer grafted chitosan can be dissolved in trifluoroacetic acid and N, N- dimethylformamide (DMF) compound in a solvent, which does not dissolve in distilled water and glacial acetic acid ; (2) the total amine value of the hyperbranched polymer grafted chitosangt; the total amine value of the hyperbranched polymer.
Keywords: Chitosan ;Hyperbranched polymer ;preparation;Microspheres
目录
摘 要 I
Abstract II
1.1超支化聚合物 1
1.1.1超支化聚合物的定义 1
1.1.2 超支化聚合物的特性 1
1.1.3超支化聚合物的用途 2
1.1.4超支化聚合物的合成 2
1.2壳聚糖 4
1.2.1壳聚糖的定义 4
1.2.2壳聚糖应用 4
1.2.3壳聚糖的改性研究 6
1.3超支化改性壳聚糖的用途 6
1.4立题依据和内容 7
1.4.1立题依据 7
1.4.2 研究内容 7
第二章 实验部分 8
2.1化学试剂和仪器 8
2.2超支化聚合物HBP接枝壳聚糖微球的制备 9
2.2.1 合成四元羧酸酯 9
2.2.2合成超支化聚合物 9
2.2.3超支化聚合物接枝壳聚糖(HBP-g-Chitosan) 10
2.2.4超支化聚合物接枝壳聚糖微球的制备 11
2.3 四元羧酸酯1HNMR谱图分析 12
2.4四元羧酸酯和HBP-NH2的FT-IR表征 12
2.5超支化聚合物的性能测试 12
2.6超支化聚合物接枝壳聚糖的性能测试 12
第三章 结果与讨论 14
3.1四元羧酸酯1HNMR谱图分析 14
3.2四元羧酸酯和HBP-NH2红外谱图分析 14
3.3 超支化聚合物性能测试结果及分析 15
3.4 HBP-g-Chitosan的性能测试 16
3.5本章小结 17
第四章 结论与展望 19
4.1结论 19
4.2展望 19
致谢 20
参考文献 21
第一章 文献综述
1.1超支化聚合物
1.1.1超支化聚合物的定义
超支化聚合物是一种具有高度支化结构的聚合物,因为超支化聚合物在物理和化学性能表现很突出,所以在很多应用领域具有很大的使用价值,在近几十年的发展中越来越得到了重视。在生物医学上,超支化聚合物合成出来的药可以对特定的疾病有很好的治疗功效;在涂料中,粘度低是超支化聚合物一大特性,使得超支化聚合物在高固体组分的涂料中广泛存在,所以超支化聚合物很受欢迎[1]。
超支化聚合物分子结构高度支化[2]。在纳米微孔内的独特分子可吸附小分子,或作为小分子反应的催化活性点[3];对于粘度、熔体粘度而言,等分子质量的超支化聚合物与线性分子相比,线性分子在粘度与熔体粘度都高于超支化聚合物,所以超支化聚合物的衍生物应用广泛[4]。
1.1.2 超支化聚合物的特性
相关图片展示:

课题毕业论文、开题报告、任务书、外文翻译、程序设计、图纸设计等资料可联系客服协助查找。
